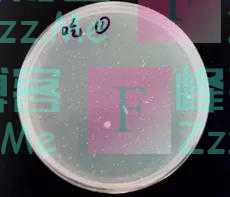

小伙伴们~
最近大家是不是也像小编一样
疯狂“吃瓜”
“吃瓜”吃到爽呢?

不过
娱乐圈的“瓜”可以大吃特吃
真正的瓜可不能随便乱吃
否则 轻则呕吐拉肚子
重则发烧食物中毒

别惊讶
小小的西瓜
如果食用方法不当
真的可以有这样大的危害!
快快看下去
一整个夏天都能健康吃瓜!
01
如果让你一口吃掉上万细菌
你愿意吗?
如果告诉你
这样的“细菌培养皿”
就藏在你家的冰箱里
是你夏天最爱吃的冰西瓜
你相信吗?

这样一块“细菌培养皿”的秘密是什么呢?
没错!隔夜西瓜!
经试验
模拟用勺子挖着吃西瓜后
将剩下的西瓜用保鲜膜包好
放入冰箱冷藏24小时
每25克西瓜中
检测出细菌1600个
而如果
将切过生肉的刀和砧板
稍加清洗后
就用来切西瓜
并将西瓜用保鲜膜包好
放入冰箱冷藏24小时
就会如上图一般
25克西瓜中
出现8400个细菌的“盛况”!

您说说
吃掉一大块这样的西瓜
得是品尝了多少细菌啊!
02
隔夜西瓜真的不能吃了吗?
可不可以再“抢救”一下了呢?
有小伙伴提出办法:
将西瓜表面一层切掉
是不是就可以放心食用了呢?

医生的答案是:不可以
据介绍
细菌如果产生毒素的话
毒素就会分泌到水果的汁液里面
汁液在水果里也要流动
所以如果毒素比较强
即使切了厚厚的一层
整个水果也已经被毒素污染
吃掉的话有生病的风险

如果一定要吃的话
建议提前将吃不完的西瓜
切好冷藏
避免用勺子挖取沾染唾液
并且使用专用切水果的刀和砧板
据实验
使用专用的刀和砧板将西瓜切块
并将西瓜用保鲜膜包好
放入冰箱冷藏24小时后
每25克西瓜中
检测出细菌45个

03
为什么隔夜西瓜
这么“毒”呢?
首先 如上文所说
如果切西瓜时
使用的刀具和砧板不干净
甚至之前切过生肉
上面的大量细菌会随之来到西瓜表面

而由于西瓜中含有大量糖分
非常适宜细菌生存
简直称得上细菌生长的“温床”
再加上如果没有用保鲜膜包好
就放入冰箱
可能与冰箱中其他腐败的食物
或是生鱼生肉接触
沾染更多的细菌

这些不当的处理方式
让“清清白白”的小西瓜
一夜之间变得“五毒俱全”
我们还怎么能
愉快的吃瓜呢?

夏日吃瓜学问多
一不小心把病得
隔夜西瓜藏细菌
快快扔掉要舍得
你喜欢吃西瓜吗?
你有哪些特别的
吃瓜、挑瓜小技巧呢?
在评论区与我分享吧~
(来源:央视网快看、新华社 实习编辑:赵若彤)
文章如无特别注明均为原创!
作者:
F_Robot,
转载或复制请以
超链接形式 并注明出处 峰哥博客。
原文地址《
一口吃掉上万细菌?!你真的会“吃瓜”吗?》发布于2021-7-23
若您发现软件中包含弹窗广告等还请第一时间留言反馈!
小米手机无法安装请到设置->开发者设置->关闭系统优化,安装后再开启系统优化。





